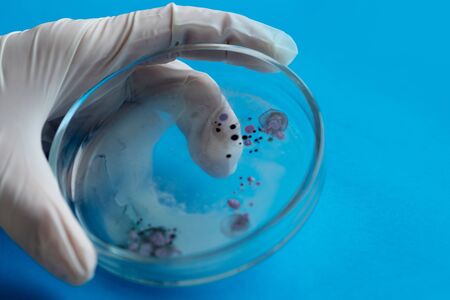
biologist or virologist holds a Petri dish with a sample. Gloved hands, close-upの写真素材

写真素材 - biologist or virologist holds a Petri dish with a sample. Gloved hands, close-up
作品情報
biologist or virologist holds a Petri dish with a sample. Gloved hands, close-up
- ID:145077068
- 作品種別:写真
- 作者名:Yulia Koltyrina
キーワード
- Petri dish
- Virology
- advanced
- analysis
- bacteria
- bacterial
- bacteriology
- biochemistry
- biological
- biology
- biotechnology
- concept
- culture
- dish
- epidemic viral pathogen
- equipment
- glassware
- gloves
- grow
- hands
- health care
- human
- hygiene
- infection
- lab
- laboratory
- laboratory assistant
- medical
- microbe
- microbiology
- microorganisms
- pandemic
- petri
- research
- sample
- science
- scientific
- scientific research
- scientist
- symbol
- test
- viral
- virus attack
- viruses
類似作品
A scientist in ...
Container with ...
Scientists look...
selective focus...
round glass to ...
GMO concept. Sc...
selective focus...
BUCHAREST, ROMA...
Forensic Scienc...
Male expert cri...
Laboratory rese...
Woman beauticia...
close-up of res...
Scientists are ...
Doctor in blue ...
Female scientis...
New breed
the doctor look...
Focused senior ...
Doctor woman or...
What do we have...
Chemical Labora...
two scientists ...
Doctor holding ...
water sample. A...
Examining bacte...
Scientist hand ...
Chronic kidney ...
Young male chem...
laboratory beak...
Woman in rubber...
Coronavirus Cov...
A man is holdin...
Caucasian men h...
The pills are i...
Police Forensic...
Portrait of a d...
Bioarcheology. ...
Gloved hand hol...
Female scientis...
A hand holds a ...
The guy in the ...
Biologist Exami...
a doctor in a w...
Putting a cotto...
science, chemis...
Front view of t...
two young women...
doctor or scien...